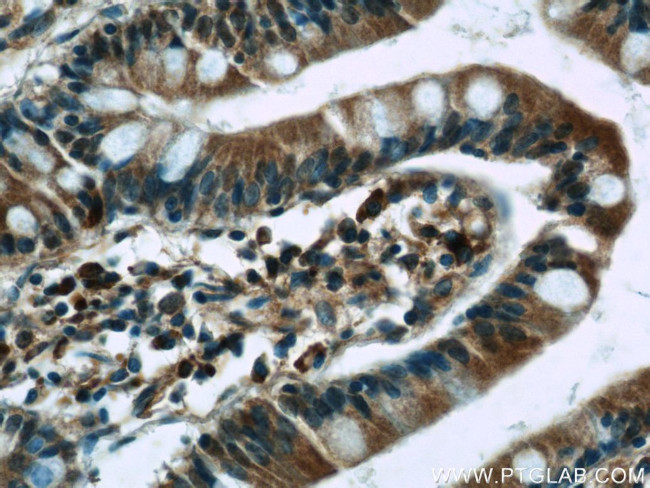
WNT6 Antibody in Immunohistochemistry (Paraffin) (IHC (P))

Search
Proteintech
WNT6 Polyclonal Antibody
{{$productOrderCtrl.translations['antibody.pdp.commerceCard.promotion.promotions']}}
{{$productOrderCtrl.translations['antibody.pdp.commerceCard.promotion.viewpromo']}}
{{$productOrderCtrl.translations['antibody.pdp.commerceCard.promotion.promocode']}}: {{promo.promoCode}} {{promo.promoTitle}} {{promo.promoDescription}}. {{$productOrderCtrl.translations['antibody.pdp.commerceCard.promotion.learnmore']}}
产品信息
24201-1-AP
种属反应
已发表种属
宿主/亚型
分类
类型
抗原
偶联物
形式
浓度
规格
纯化类型
保存液
内含物
保存条件
运输条件
产品详细信息
Immunogen sequence: DPTSICRKA RRLAGRQAEL CQAEPEVVAE LARGARLGVR ECQFQFRFRR WNCSSHSKAF GRILQQDIRE TAFVFAITAA GASHAVTQAC SMGELLQCGC QAPRGRAPPR PSGLPGTPGP PGPAGSPEGS AAWEWGGCGD DVDFGDEKSR LFMDARHKRG RGDIRALVQL HNNEAGRLAV RSHTRTECKC HGLSGSCALR TCWQKLPPFR EVGARLLERF HGASRVMGTN DGKALLPAVR TLKPPGRADL LYAADSPDFC APNRRTGSPG TRGRACNSSA PDLSGCDLLC CGRGHRQESV QLEENCLCRF HWCCVVQCHR CRVRKELSLC L (36-365 aa encoded by BC004329)
靶标信息
The WNT gene family consists of structurally related genes which encode secreted signaling proteins. These proteins have been implicated in oncogenesis and in several developmental processes, including regulation of cell fate and patterning during embryogenesis. This gene is a member of the WNT gene family. It is overexpressed in cervical cancer cell line and strongly coexpressed with another family member, WNT10A, in colorectal cancer cell line. The gene overexpression may play key roles in carcinogenesis. This gene and the WNT10A gene are clustered in the chromosome 2q35 region. The protein encoded by this gene is 97% identical to the mouse Wnt6 protein at the amino acid level.
仅用于科研。不用于诊断过程。未经明确授权不得转售。
生物信息学
蛋白别名: Mutations: 918:OK; Protein Wnt-6; unnamed protein product; wingless-related MMTV integration site 6; wingless-type MMTV integration site family, member 6
基因别名: AA409270; Wnt-6; WNT6
UniProt ID: (Human) Q9Y6F9, (Mouse) P22727
Entrez Gene ID: (Human) 7475, (Mouse) 22420